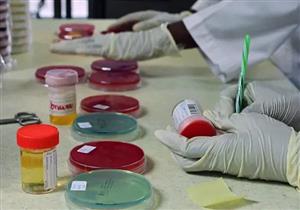
تحليل المنشطات للرياضيين- هل أدوية التخسيس تؤثر على نتيجته؟

أخبار متعلقة بــ
تحليل المنشطات
-
ليبو 6 للتخسيس- كيف يؤثر على تحليل المنشطات؟

يستعرض "الكونسلتو" في التقرير التالي، تأثير دواء ليبو 6 للتخسيس على تحليل المنشطات.
-
للرياضيين- ما هي الأدوية التي تظهر في تحليل المنشطات؟

يستعرض "الكونسلتو" في التقرير التالي، أبرز الأدوية التي تظهر في تحليل المنشطات.
-
تحليل المنشطات للرياضيين- هل أدوية التخسيس تؤثر على نتيجته؟
يستعرض "الكونسلتو" في التقرير التالي مخاطر ادوية التخسيس على اللاعبين ومدى ظهورها في تحليل المنشطات.
- المزيد
مختارات لا تفوتك
-
 أخبار مطبخك الصحي
أخبار مطبخك الصحيالفاكهة وإنقاص الوزن- هل تساعد على حرق الدهون؟
يتجنب بعض الأشخاص تناول الفاكهة أثناء الرجيم، لكن الدراسات تشير إلى أن الفاكهة الكاملة قد تكون من أفضل الأطعمة الداعمة لخسارة الوزن
-
 أخبار مطبخك الصحي
أخبار مطبخك الصحيالبروتين لخسارة الوزن- كيف يساعدك على حرق الدهون وتقليل الشهية؟
يُعد البروتين من أهم العناصر الغذائية التي تساعد على إنقاص الوزن، إذ لا يقتصر دوره على بناء العضلات، بل يساهم أيضًا في تقليل الشهية، وزيادة معدل حرق السعرات الحرارية
-
 أمراض مزمنة
أمراض مزمنةالسكري من النوع الثاني- هل يزيد خطر الإصابة بالاكتئاب؟
لا تقتصر مضاعفات السكري من النوع الثاني على القلب أو الكلى أو الأعصاب فقط، إذ تشير دراسة حديثة إلى أن المرض قد يرتبط أيضًا بزيادة خطر الإصابة ببعض الاضطرابات النفسية
-
 نصائح
نصائحاختلال التوازن الهرموني.. متى يشير للخطر؟
التوازن الهرموني. اختلال التوازن الهرموني. أسباب اختلال التوازن الهرموني. أعراض تشير لاختلال التوازن الهرموني. طرق علاج اختلال التوازن الهرموني.
-
 نصائح
نصائحنقص الفيتامينات.. إليك الأسباب والأعراض وطرق العلاج السريعة؟
الفيتامينات. نقص الفيتامينات. أسباب نقص الفيتامينات. أعراض مصاحبة لنقص الفيتامينات. طرق السيطرة على نقص الفيتامينات. وسائل للحد من نقص الفيتامينات.
-
 أخبار مطبخك الصحي
أخبار مطبخك الصحيهل تشعر بانزعاج بعد تناول الطماطم والفلفل؟.. اعرف حساسية الباذنجانيات
حساسية الباذنجانيات. الطماطم. الفلفل. الباذنجان. البطاطس. البطاطا. الطماطم. الفلفل الحلو. الباذنجان. الفلفل الحار. الإسهال. ألم البطن. الانتفاخ. الغثيان. انتفاخ البطن.
-
 أخبار صحة
أخبار صحةنقابة العلاج الطبيعي ترفض أي توصيات بشأن الأطراف الصناعية.. تفاصيل
نقابة العلاج الطبيعي. كلية العلاج الوظيفي. تخصص العلاج الوظيفي. الأطراف الصناعية. حقوق المرضى والمسنين. الصحة. السكان. قانون إنشاء نقابة العلاج الطبيعي.
-
 نصائح
نصائحعادات صحية يومية تقلل من فرص الإصابة بالأمراض.. احرص على اتباعها
عادات صحية. عادات يومية. الإصابة بالأمراض. عادات للتخلص من الأمراض. طرق التخلص من الأمراض. طرق يومية تحمي من الأمراض. عادات صحية يومية. عادات يومية خاطئة.
-
 أخبار الأسنان
أخبار الأسنانحساسية معجون الأسنان.. طبيب يوضح أعراض خطيرة تستدعي التدخل
حساسية معجون الأسنان. رد الفعل التحسسي لمعجون الأسنان. النكهات الصناعية. لوريل الصوديوم. إحساس بالحرقان. الحكة حول الفم. تهيج اللسان. تقشر الشفاه. الجلد المحيط بالفم.
-
 أمراض مزمنة
أمراض مزمنةتمزق غضروف الركبة.. طبيب يوضح الأعراض التي تحتاج للجراحة؟
غضروف الركبة. الرياضيين. كبار السن. الألم الشديد. التورم المفاجئ في المفصل. إصابة الركبة. أنواع غضروف الركبة. إصابات الركبة. الغضروف المفصلي. جراحة العظام.











